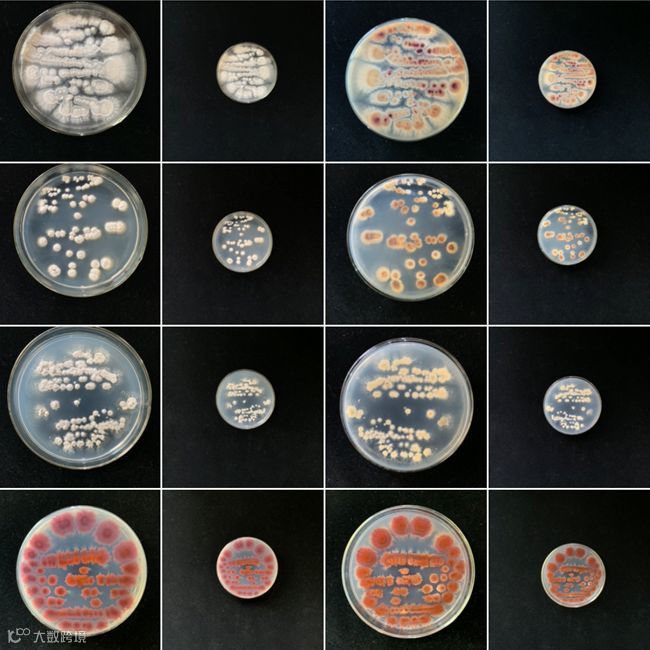
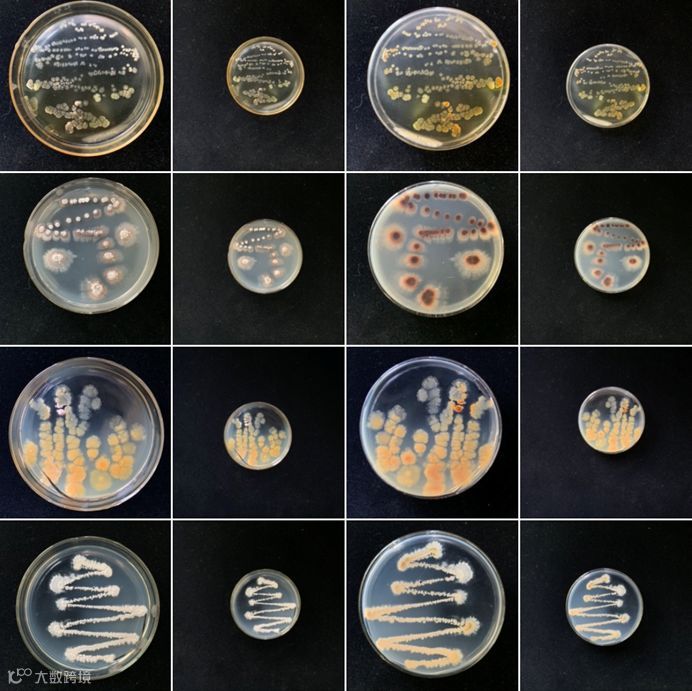

—生化学院第九届—
感
化
学
之
美
投·票
实验作品
摄影比赛
记
生
命
永
恒
2020年的第一个选择来啦~
你以为实验室还是破旧冷清的吗?
你以为实验人还是古板呆滞的吗?
关注实验作品摄影大赛,
带你领略不一样的科研生活。

本次实验室摄影大赛共收到了49份作品
经过评委老师的筛选与评分
有20份作品脱颖而出
来到了最终线上投票环节
此环节占总分值的50%
投票截止时间1月3日22:00
让我们一起走进看看美丽的摄影作品吧

曹磊
植物生理实验室记忆


第一张:杨冬梅副教授和Tyree教授在实验室就试验方法问题进行指导,对实验细节问题进行实际性的测试,每一步过程都很注意。
第二张:植物水分生理实验室课题组成员对实验室外面培育的实验用材进行浇水,施肥。
程丽丽
不一样的“我”

“我”是草酸根合铁(III)酸钾晶体,是以草酸钾和六水合三氯化铁为原料,制备出一种有机反应良好的催化剂。“我”是一种绿色的单斜晶体,不仅长得光鲜亮丽,而且在工业上也有很大的应用价值。另外,“我”还会变魔术,见光会分解成黄色。正因为不一样的“我”,所以要参加此次的选美大赛,希望大家捧捧场,给我点个赞!
薛琛 谢子玉
小甘“鼠”

你见过小甘“鼠”吗?白白胖胖的身体,细细长长的尾巴,还有两颗灵动的眼睛,一切都是那么的恰到好处。这不正体现了大自然的奇妙之处,而我们就是大自然的探索者,正一点一点揭开它的神秘面纱。
黄林洁 吴晓敏
蒸馏绿芒


时光匆匆,光阴流转,斑驳的蒸馏瓶,记录着它奋斗的痕迹,夕阳扫过格子间的安静,岁月的温和安好,共赏一捧青花,何惧刹那芳华,最是那一抬头的绿意,忙忙碌碌,清清爽爽,可可爱爱。
郭鑫
日常


我所拍摄的题材是根据我们实验室的日常科研生活选择的,一张是柱层析的分离图,一张是平时所用的滤膜,用于过滤除菌。都是一些简单的器材,但是也正是因为这些简单的器材我们能够继续我们的科研进程,实现我们自己的科研目标。
廉院训
稻园

远处夕阳,近处花朵,背后是一片广阔的稻田,此刻,它们交错在一起,多么美妙与和谐!我们在那里劳作,在那里欢快,在那里感受大自然,这张照片记录了水稻田园生活的一部分。
熊祖平
近红外有机荧光新骨架


该新有机分子是在做某个反应时意外发现的,但是它高量子效率的红光深深吸引了我(高亮红光分子十分罕见),而且还是溶液固体双态发光。经过不断探索,目前产率和纯度都得到大大提高。在荧光分子领域,近红外还是双态发光的分子还是个难题,正是因为红光能应用于生物探针,避免生物背景的干扰,所以具有极大应用价值。目前这个策略还具有普适性,可通过骨架衍生得一系列红色荧光分子。
顾家家
生命的力量

这张照片展示了培养器中番茄种子发芽的过程。这个实验的目的是检测种子的发芽程度、发芽速度和发育成作物的快慢。研究结果对于番茄育种有着重要意义。
通常人们提到科学研究时,总会想到超级计算机、太空探险和细菌培养,然而这些似乎都与他们的日常生活无关,而这张照片清楚地说明了许多科学研究与我们的生活息息相关。人们日常生活中每天遇到的事物——比如超市的番茄——背后也有科学和好奇心。
苏俊青 陶彩萍
璀璨“锌”辰

化学之美,在于用简单的操作幻化出多姿之态。图中的璀璨“锌”辰是通过电化学STM针尖诱导纳米构筑的方法做成的。对金针尖施加一定的电位使溶液中的锌离子沉积到针尖上,再通过软件驱使针尖前伸,使针尖上的金属锌沉积到Au(111)基底上。由于STM具有原子级的分辨率,便形成了如下夜空星辰般的图案,这与生活中的书法有异曲同工之妙。
周雅 刘金莲
万能的模式植物



俞蕾 王小青
小科研大硕果

顽强的毅力能够征服世界上任何一座高峰,番茄作为模式植物的一种在各个基因的功能验证中起着至关重要的作用,就如同我们作为生化人的一份子,虽然如同颗颗番茄在生物届中一样的渺小,但是我们有顽强毅力用心学术就能征服科研道路上任何一座高峰。
张云 蒋莹佩

白色既是纯洁无瑕,也是不负初心;咖啡色既是庄重雅致,也是含蓄不张扬;墨绿色既是蓬勃向上,也是沉稳安静;粉色既是天真烂漫,也是美好追求,五彩斑斓的世界,五彩斑斓的我们。
李可 顾莉莉
平凡

你可能见过冬日的腊梅挂满枝头,见过初夏的蓝莓开出白色的小花,但是我们见过十二月的蓝莓在温室里默默绽放,悄无声息的,只是一次无意的发现,让我们在平凡的日子里获得些许热闹,所以也想让你与我们共同分享这份喜乐。
霍达 熊姗姗
夜空中最亮的星

在钴化合物的世界里,有各种各样的形貌,或纳米微球形貌,或片状形貌,或立方体形貌,最重要的就是需要一个合适完美的配体。经过温度的淬炼,六边形Co(OH)2核和Co(OH)F边完美契合形成六芒星。茫茫星海,遇见最完美的你。
邢怡晨 张莹
遇见微光

光影如斯兮,岁月如梭。实验室中丰富多彩的科研生活,成就斑驳绚丽的画卷。此图为多种荧光物质拍摄,每一种都散发着其独特的光芒。在祖国成立七十周年之际,因为师大我们像星星点点一般汇聚在此,而科研路上的你我,无数次辛勤付出,总会有光彩夺目的瞬间。
倪峰
大地的陈述

浙师大土地肥沃,土壤中有许多放线菌,以上两图是从浙师大樱花林和叠翠园收集的土壤,后分离纯化得到的放线菌。我们使用的60%的抗生素来自放线菌,放线菌不仅色彩夺目且利用价值极高。
曹潇楠 刘倩
印象科研

容量瓶虽小,但却容得下不少瓶瓶罐罐的药品,只要有心,就能见证奇迹。在实验中存在很多不起眼的仪器和现象,只要用心观察,就能收获奇迹。
高原
桃李芬芳满天下

人间四月芳菲尽,随着时光的流转,桃花谢了春红,李花隐了芳踪,唯独留下那毫不掩饰的欣喜和硕果累累的期盼。
愿 桃李芬芳满天下,教泽绵长遍九州。
张吟霜
荧光

此图为硅胶注入法测量导管长度,图中的荧光是我要寻找的部分,代表着实验的成功,代表着希望。这个实验需要将一段长枝条一点点的切片观察,每当想放弃时,是这些美丽的荧光给了我动力
周莎莎 郭思丹
是心动啊

此图是由具有两种不同荧光颜色的纯有机化合物拼构而成。这高高低低起起伏伏的心电曲线犹如我们的科研和人生,它不会呈现出一帆风顺,但是 它一定会在某个瞬间、某个转角处带给我们莫名的心跳,这种感觉——是心动啊!

看过那么多照片,
是不是颠覆了你对实验室的想象?
那就赶紧动手,
为你喜欢的作品添砖加瓦吧~
···THE END···
编辑:杭书勤
投稿邮箱:1105388014@qq.com

好玩的校园资讯
长按二维码进行互动
☟

浙师大生化学院研会官方微信


